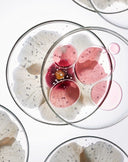
Close-up of flower petals and serum encapsulated in clear liquid within glass petri dishes, symbolizing Audrose®’s microencapsulation technology that enhances hydration, protection, and calming benefits for sensitive skin.

Justine Nichole’s journey to launching Audrose® began with a deeply personal mission: to heal her own skin from the effects of chronic inflammation caused by an autoimmune disease. As a registered nurse with over 15 years of experience in healthcare, Justine combined her clinical knowledge with her personal passion for wellness to create a skincare line that bridges the gap between science and nature.
After years of testing top products and consulting with renowned specialists across the country, with little lasting success, Justine partnered with a leading cosmetic chemist to develop a solution of her own.
The result: Phyto-Molecular Skin Science®, a multi-patent innovation at the heart of Audrose®, designed to calm inflammation, support skin barrier function, and deliver visible, lasting results, even for the most sensitive skin.
"Creating Audrose® has been an incredibly rewarding journey. Seeing the transformation in my own skin was meaningful, but witnessing the visible results in others, through clinical studies and personal testimonials, has been truly powerful. The greatest reward is hearing how Audrose® has not only improved the look and feel of their skin, but also positively impacted their confidence and emotional well-being.”
– Justine Nichole, CEO and Founder
Audrose® reflects Justine’s uncompromising standards: high-performance formulas, clean botanical actives, and a commitment to gentle, effective skincare for all.
The Audrose® Ethos
Purpose
To redefine care for sensitive skin through uncompromising science and extraordinary precision. At Audrose®, we believe sensitivity is not a limitation, but a complexity worthy of innovation and respect.
Promise
Our patented Phyto-Molecular Skin Science® goes beyond surface solutions to treat concerns at the cellular level, restoring harmony where it begins. Every formula is designed to deliver visible transformation while remaining gentle, ethical, and sustainably developed.
Philosophy
We craft skincare anchored in authenticity, guided by intention, and dedicated to community. With compassion at our core, we create products that not only transform skin but also embody trust, integrity, and care without compromise.